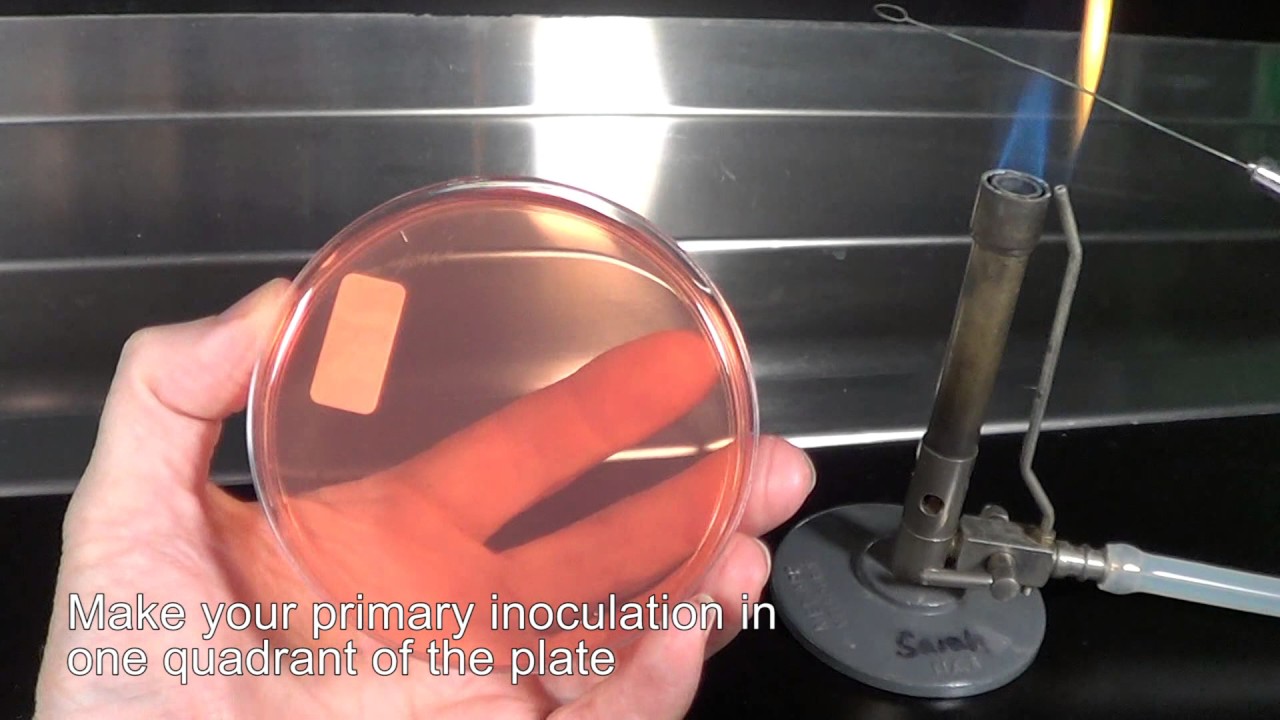
Streaking for single colonies

Isolation of single bacterial colonies скачать в хорошем качестве
Повторяем попытку...

Скачать видео с ютуб по ссылке или смотреть без блокировок на сайте: Isolation of single bacterial colonies в качестве 4k
У нас вы можете посмотреть бесплатно Isolation of single bacterial colonies или скачать в максимальном доступном качестве, видео которое было загружено на ютуб. Для загрузки выберите вариант из формы ниже:
-
Информация по загрузке:
Скачать mp3 с ютуба отдельным файлом. Бесплатный рингтон Isolation of single bacterial colonies в формате MP3:
Если кнопки скачивания не
загрузились
НАЖМИТЕ ЗДЕСЬ или обновите страницу
Если возникают проблемы со скачиванием видео, пожалуйста напишите в поддержку по адресу внизу
страницы.
Спасибо за использование сервиса ClipSaver.ru
Isolation of single bacterial colonies
Welcome to our suite of NUI Galway Microbiology teaching videos. We hope that they will guide you in performing your experiments in a scientific and safe manner. This video describes how to perform a “3 way streak”. This is one of the most fundamental techniques that you should master as a microbiologist. It leads to isolated bacterial colonies that are necessary in applications such as bacterial identification and gene cloning.

![Эффект Джанибекова [Veritasium]](https://imager.clipsaver.ru/N9HlQ-XVnFk/max.jpg)




